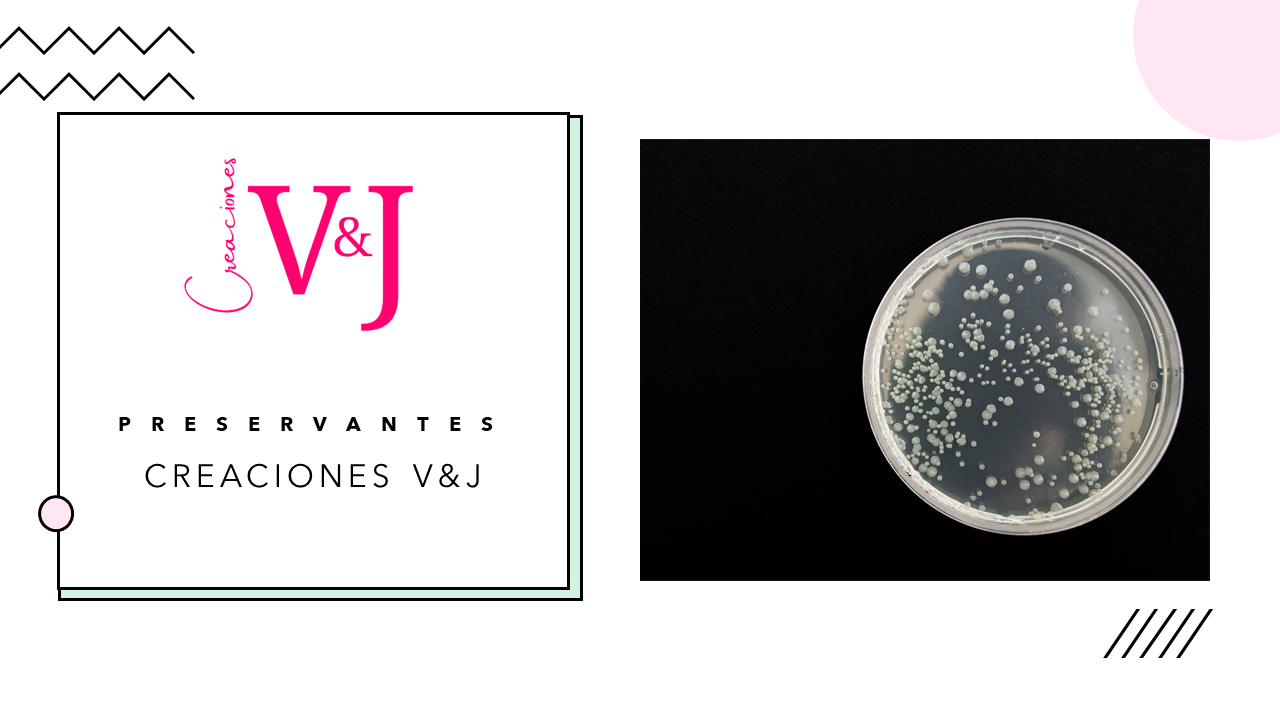
MANUAL DE PRESERVANTES

1
/
of
1
CREACIONES V&J
MANUAL DE PRESERVANTES
MANUAL DE PRESERVANTES
Regular price
$3.99 USD
Regular price
Sale price
$3.99 USD
Unit price
/
per
Shipping calculated at checkout.
Couldn't load pickup availability
Conoce sobre los beneficios de los preservantes asi como sus usos y limitaciones con nuestro Manual de Preservantes. En este manual discutiremos los preservantes mas comunes para que pueda elegir correctamente el adecuado para su producto.
Share